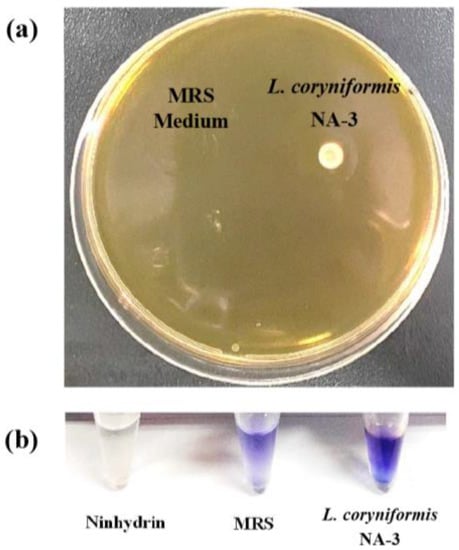

Abstract
Some Latiactobacilli are often used as probiotics due to their functional activities, including antioxidant, anticancer and immunoregulation effect. Loigolactobacillus coryniformis NA-3 obtained from our laboratory is a promising probiotic according to the previous study. Coculture, the Oxford cup test and disk-diffusion methods were used to evaluate the probiotic properties and antibiotic resistance of L. coryniformis NA-3. The antioxidant activities of live and heat-killed L. coryniformis NA-3 were assessed via radicals’ scavenging ability. The potential anticancer and immunoregulatory capacity was determined in vitro using cell lines. The results indicate that L. coryniformis NA-3 has antibacterial activity and cholesterol removal ability and is sensitive to most antibiotics. Dead L. coryniformis NA-3 can scavenge free radicals as well as live strains. Live L. coryniformis NA-3 can significantly inhibit the proliferation of colon cancer cells; however, dead cells cannot. After RAW 264.7 macrophages were treated with live and heat-killed L. coryniformis NA-3, the production of NO, IL-6, TNF-α and reactive oxygen species (ROS) was induced. The increased expression of inducible nitric oxide synthase (iNOS) in treated macrophages mediates the production of NO. In conclusion, L. coryniformis NA-3 showed potential probiotic properties, and the heat-killed strain also exhibited activities similar to those of live bacteria, suggesting the possible value of its further application in the food processing and pharmaceutical industries.
1. Introduction
Lactic acid bacteria (LAB) are a group of lactic-acid-producing, Gram-positive, non-spore-forming, catalase-negative, anaerobic or microaerophilic, cocci or rods [1]. There are many species of LAB, including Enterococcus, Lactobacillus, Pediococcus, Streptococcus, Lactococcus, Vagococcus, Leuconostoc, Oenococcus, Weissella, Carnobacterium and Tetragenococcus, which are general microflora in both human and animal GITs [2]. Some LAB are commonly considered probiotics and generally recognized as safe (GRAS) [3]. Probiotics are defined by the Food and Agriculture Organization (FAO) of the United Nations and the World Health Organization (WHO) as “live microorganisms which when administered in adequate amounts confer a health benefit on the host” [4,5]. Probiotics can confer many benefits such as immunomodulation, lipid and cholesterol reduction, anticancer, antimicrobial and antioxidative properties, prevention of gastrointestinal infections, improvement of lactose metabolism, etc. [6,7]. The functional properties of a probiotic strain can be evaluated via various in vitro tests. The scavenging of free radicals is generally used for the in vitro evaluation of antioxidant activity, and cell experiments are effective methods of estimating biological activities such as anticancer and immunomodulation effects.
Reactive oxygen and free-radical species (ROFRs) are a group of highly reactive radicals and non-radical chemicals that can be produced during normal metabolism in the body and maintained at physiological levels by the work of endogenous enzymatic and non-enzymatic scavengers [8]. They fulfill various important biological functions such as cellular signaling, proliferation, apoptosis, regulation of gene expression and innate immunity to fight pathogens at suitable concentrations [8]. When ROFRs exceed the body’s own antioxidant capacity (AOC), they cannot be neutralized by the endogenous antioxidant system, which will lead to damage to the proteins, nucleic acids, lipids and carbohydrates of cells and tissues due to oxidation [9]. Ultimately, redundant ROFRs promote chronic diseases such as Parkinson’s disease, Alzheimer’s disease, atherosclerosis, arthritis, diabetes, neurodegenerative diseases, cardiovascular disease and cancer [8]. Therefore, it is necessary to clear harmful ROFRs to maintain the host’s health. Exogenous regulation and reasonable dietary antioxidant supplements are adopted means of controlling oxidative stress. Most LAB are equipped with scavenging systems for oxygen free radicals, possess antioxidant activity and can be used as alternatives for the production of functional foods or natural antioxidant supplements [10]. It is reported that viable cells of Lactobacillus plantarum 200655 isolated from kimchi can scavenge 1,1-diphenyl-2-picryl-hydrazyl (DPPH) and 2′-Azinobis-(3-ethylbenzthiazoline-6-sulphonate) (ABTS) free radicals and inhibit the oxidation of β-carotene and linoleic acid, showing significant antioxidant activity [11]. Intact cells of Lactobacillus acidophilus ATCC 4356 also show good antioxidative activity in terms of inhibiting linoleic acid peroxidation and scavenging DPPH free radicals [12]. Furthermore, both live and heat-killed L. plantarum Ln1 showed DPPH and ABTS scavenging activities and β-carotene bleaching inhibitory activity [13].
Studies have shown that live cells of probiotic bacteria have immune-potentiating effects [4]. For instance, L. plantarum BF_15 isolated from the feces of breast-fed infants could regulate intestinal microbiota dysbiosis in mice and expressed a potential immunomodulatory function [14]. Back in the 1900s, it was reported that L. acidophilus could promote the production of flavonoids by improving the activity of β-glucosidase, leading to antimutagenic, antioxidative and immune-stimulatory effects [15,16]. Lactobacillus casei CRL 431 administration in healthy mice increased the expression of Toll-like receptors (TLRs) and induced the secretion of cytokines, improving the immune response against Salmonella enterica serovar Typhimurium infection in mice [17]. Components of cell walls such as peptidoglycan (PG), lipoproteins (LP) and other proteins can be recognized by recognition receptors on the surface of host immune cells, activating the immune system [18]. Studies have shown that many functional effects obtained from viable cells of probiotics are also obtained from populations of dead cells [19], which may be closely related to the innate components of the bacterial cell wall. There have been reports that inactivated probiotic cells also stimulate the immune response via in vitro or in vivo evaluations. Nanometric heat-treated L. plantarum LM1004 isolated from Korean kimchi was shown to effectively induce the secretion of tumor necrosis factor-α (TNF-α) and interleukin 6 (IL-6) and to increase the expression of inducible nitric oxide synthase (iNOS) of macrophages in vitro [20]. Moreover, the oral administration of L. plantarum LM1004 also increased the splenocyte proliferation and serum cytokine levels in mice, suggesting good immunoregulatory activity in vivo [20].
Though the LAB used in the food, feed and pharmaceutical industries generally show many functional activities, there are still many issues to be solved. Live bacteria are easily degraded and mutated, hard to preserve, hard to transport, at risk for transfer of resistance genes in long-term use, likely to cause allergies and so on. Therefore, the development of novel probiotics is necessary. With the advancement of research, many functional activities similar to those of viable cells have been reported in dead LAB, which also represents an alternative method of solving the practical application problems of live bacteria. An exopolysaccharide (EPS)-producing Latilactobacillus was isolated from Chinese sauerkraut in our laboratory and was named Lactobacillus coryniformis NA-3. It has been known as Loigolactobacillus coryniformis since 2020, as its genus was reclassified. L. coryniformis almost never appears in various processing industries. However, our previous study showed that the EPS on the surface of L. coryniformis NA-3 exhibited antioxidant and biofilm-inhibiting properties [21]. This study focused on the further probiotic characteristics of the bacterial cell itself, including its antioxidant, anticancer and immune-enhancing activities. This study shows important research significance in terms of both probiotic development and solving the problem of live probiotics being used in applications.
2. Materials and Methods
2.1. Bacterial Strains and Culture Conditions
Foodborne L. coryniformis NA-3 was obtained from our own laboratory and isolated from Chinese sauerkraut. The bacteria stored at −80 °C was cultured in solid Man, Rogosa and Sharpe (MRS) (Solarbio, Beijing, China) broth at 37 °C for 48 h. A single colony of L. coryniformis NA-3 was transferred into 10 mL of MRS broth and grown at 37 °C for 48 h under anaerobic conditions. Bacillus cereus (CICC 21261), Salmonella enterica subsp. enterica serovar Typhimurium (CICC 22956/ATCC 14028) and Escherichia coli O157:H7 (CICC 10907) were purchased from the China Center of Industrial Culture Collection (CICC), and Staphylococcus aureus (CGMCC 1.291) was purchased from the China General Microbiological Culture Collection Center (CGMCC). The four pathogenic bacteria were grown in trypticase soy broth (TSB) solid medium at 37 °C for 24 h under aerobic conditions. A single colony was transferred into 5 mL of fresh TSB broth and grown for 24 h at 37 °C with shaking. A one-percent bacterial suspension (108 CFU/mL) was inoculated in another 5 mL of fresh TSB medium and cultured for 24 h at 37 °C with continuous shaking in order to obtain a pathogenic bacteria suspension for the following applications.
2.2. Antibiotic Susceptibility
The disk diffusion method operates according to the principle that an antibiotic-impregnated disk placed on agar previously inoculated with the test bacterium picks up moisture, and the antibiotic diffuses radially outward through the agar medium, producing an inhibition zone [22]. In this study, the disk-diffusion method was used to evaluate the antibiotic susceptibility of L. coryniformis NA-3. Thirty antibiotic discs (BKMAM, Changde, China) were used in this study. The types, contents and judgment standards [23,24] of the antibiotics are listed in Table 1. The measurements were taken as follows. Antibiotic paper was placed on the surface of a Petri dish containing L. coryniformis NA-3 incubated at 37 °C for 24 h under anaerobic conditions. The diameter of the transparent circle was measured and expressed in millimeters.

Table 1.
Types, names, contents, and judgment standards of 30 kinds of antibiotics.
2.3. Probiotic Properties of L. coryniformis NA-3
2.3.1. Antibacterial Activity
Cocultivation
The antibacterial activity of L. coryniformis NA-3 was first assessed using the method of cocultivation with B. cereus, S. Typhimurium, E. coli O157:H7 and S. aureus according to the method described in our previous report [25]. The survival rate (%) of each pathogen was calculated as (CFU of pathogen in coculture system)/(CFU of pathogen in monoculture system) × 100%. CFU means colony-forming units.
Bacteriostatic Circle
The antibacterial ability of Latilactobacillus was measured using its supernatant and the Oxford cup method. L. coryniformis NA-3 was transferred into an 8 mL fresh MRS broth with 1% inoculation and grown for 24 h. The suspension was centrifuged at 10,000 r/min for 5 min. The supernatant was collected and used for the following bactericidal test. The pH of the supernatant was 4.0 after determination. B. cereus, S. Typhimurium, E. coli O157:H7 and S. aureus were also used for bacteriostatic circle tests. MRS medium (original pH 6.0) was used as a blank control. The supernatants of L. coryniformis NA-3 with the pH adjusted to 7.0 and MRS broth with the pH adjusted to 4.0 were also assessed to analyze the antibacterial effect. Petri dishes were placed at room temperature, and bacteriostatic tests were conducted on the following day.
2.3.2. Cholesterol Removal and Bile Salt Hydrolase Production
The Oxford cup test was performed to identify the abilities of cholesterol degradation and BSH production using a Petri dish supplemented with 0.005% cholesterol. One hundred microliters of L. coryniformis NA-3 (109 CFU/mL) was added into an Oxford cup, and MRS medium was used as the control. The Petri dish was incubated at 37 °C for 24 h under anaerobic conditions. The appearance of a white precipitating circle indicates cholesterol removal ability and BSH production. The white precipitate was mixed with ninhydrin solution and boiled for 5 min. A color reaction further confirmed the production of BSH.
2.4. Preparation of Live and Heat-Killed L. coryniformis NA-3 Cells
One milliliter of L. coryniformis NA-3 was inoculated in 100 mL of MRS medium and grown for 16 h at 37 °C under anaerobic conditions. The bacterial suspension was centrifuged at 12,000 rpm for 5 min. Cells were collected and washed twice with sterile phosphate-buffered saline (PBS, 0.01 M, pH 7.4). Finally, the precipitate was resuspended in sterile PBS and adjusted to 108 CFU/mL as a sample of live strains for the next experiment. Half the volume of the bacteria suspension (108 CFU/mL) was heat killed at 80 °C for 10 min in a water bath as a sample of heat-killed strains [26].
2.5. Observation of Live and Heat-Killed L. coryniformis NA-3 with Scanning Electron Microscope (SEM)
Live and heat-killed L. coryniformis NA-3 were observed using a Hitachi SU8010 scanning electron microscope (Hitachi, Tokyo, Japan) as described in our previous report [25].
2.6. Antioxidant Activity of Live and Heat-Killed L. coryniformis NA-3
2.6.1. ABTS Scavenging
The ABTS-radical-scavenging activity assay using live and heat-killed L. coryniformis NA-3 was carried out as described by Song et al. [27], with a few modifications. The mixture of 400 μL of ABTS (Solarbio, Beijing, China) working solution (OD734 = 0.700 ± 0.02) and 100 μL of live/heat-killed strains was referred to as “Ai”. The mixture of 400 μL of ABTS solution (OD734 = 0.700 ± 0.02) and 100 μL of PBS (10 mM, pH 7.4) was referred to as “Ao”. All experiments were performed in triplicate. The mixtures were shocked and left for 6 min in the dark. Two hundred microliters of reaction supernatant was added to a 96-well plate after centrifugation (12,000 rpm for 5 min), and we measured the OD734 immediately.
The scavenging activity (%) = (ODAo − ODAi)/ODAo × 100%
2.6.2. DPPH Scavenging
The scavenging activity of live and heat-killed L. coryniformis NA-3 on DPPH (MACKLIN, Shanghai, China) free radicals was determined as follows [27]. Suspensions of viable and heat-killed L. coryniformis NA-3 (108 CFU/mL) were used for assessment, respectively. The mixture of live/heat-killed L. coryniformis NA-3 with DPPH was centrifuged at 12,000 rpm for 5 min, the supernatant of the reaction was added to a 96-well plate, and we measured the OD517. PBS was used as the negative control. Each experiment was performed in triplicate.
The scavenging activity (%) = (ODnegative control − ODsample)/(ODnegative control) × 100%
2.6.3. Nitric Oxide Scavenging
The nitric oxide scavenging activity of the live and heat-killed L. coryniformis NA-3 was measured according to a modified version of the protocol described by Tsai et al. [28]. The supernatant of the reaction was determined at 550 nm. PBS was used as the negative control. Each experiment was performed in triplicate.
The scavenging activity (%) = (ODnegative control − ODsample)/(ODnegative control) × 100%
2.6.4. Hydroxyl Radical Scavenging
The hydroxyl-radical-scavenging activity of live and heat-killed L. coryniformis NA-3 was evaluated according to our previous protocol, with a few modifications [29]. Live/heat-killed strains were added to the basic reaction system and referred to as “As”. PBS was mixed as “Ac”. The “Ao” group involved changing H2O2 and the sample to H2O and PBS. Each experiment was performed in triplicate. The supernatant of the reaction was added to a 96-well plate, and we immediately measured the optical density at 536 nm.
The scavenging activity (%) = (ODAs − ODAc)/(ODAo − ODAc) × 100%
2.6.5. Superoxide Free Radical Scavenging
The superoxide free radical scavenging of live and heat-killed L. coryniformis NA-3 was also determined using the method reported in [29], with a few modifications. The reaction system was prepared as follows: 100 μL of Tris (Solarbio, Beijing, China)-HCl (Beijing Chemical Works, Beijing, China) buffer (pH 8.0, 150 mM), 50 μL of 1,2,3-phentriol (Sinopharm Chemical Reagent Co., Ltd, Shanghai, China) (1.50 mM, dissolved with 10 mM HCl) and 200 μL of different samples referred to as “A11”. A mixture of Tris-HCl buffer, 10 mM of HCl and different samples was referred to as “A10”. A mixture of Tris-HCl buffer, 1,2,3-phentriol and PBS was referred to as “A01”. A mixture of Tris-HCl buffer, 10 mM HCl and PBS was referred to as “A00”. Each experiment was performed in triplicate. All reactions were vortexed and kept for 30 min in the dark at room temperature. After centrifugation (12,000 rpm for 5 min), 200 μL of supernatant was added to a 96-well plate, and then the OD325 was determined immediately.
The scavenging activity (%) = [1 − (ODA11 − ODA10)/(ODA01 − ODA00)] × 100%
2.7. Anticancer Activity of Live and Heat-Killed L. coryniformis NA-3
HT-29 cells, purchased from Beijing Dingguo Changsheng Biotechnology Co., Ltd. (Beijing, China), were used to assess potential anticancer activity of live and heat-killed L. coryniformis NA-3. The cells were cultured as described in our previous work on macrophages [30]. Fifty thousand cells were seeded in a 96-well plate and grown overnight. HT-29 cells in a 96-well plate were treated with different dosages (106 CFU/mL, 107 CFU/mL and 108 CFU/mL) of live/heat-killed L. coryniformis NA-3 in quadruplicate and cultivated for 24 h. After the cell supernatant was abandoned, the MTS method was used to determine the cell proliferation. The anticancer activity was measured via the proliferation result of HT-29 cells, which was expressed as percentage of OD490 relative to the negative control.
2.8. The Immunoregulatory Activity of Live and Heat-Killed L. coryniformis NA-3
RAW 264.7 macrophages were purchased from Beijing Dingguo Changsheng Biotechnology Co., Ltd and cultured using our previous method [30].
2.8.1. Determination of Nitric Oxide
One hundred thousand cells in each well were seeded in a 96-well plate (100 μL/well) and grown for 24 h. A suspension (108 CFU/mL) of live/heat-killed strains in PBS was centrifuged and resuspended in DMEM medium, supplemented with 10% FBS, and 1% penicillin–streptomycin, then diluted to 107 CFU/mL and 106 CFU/mL with DMEM medium containing 10% FBS. Then, the cells were treated with different concentrations of strains. Cells grown in complete DMEM medium were regarded as negative controls. All experiments were performed in quadruplicate.
After 24 h of treatment, the cultured supernatant was collected, and NO production was analyzed via a Griess assay [29]. The absorbance at 550 nm was read using a Synergy H1 microplate reader (BioTek, Winooski, VT, USA). The linear relationship between the concentrations of sodium nitrite and the absorbance was analyzed. The NO production was calculated based on the sodium nitrite standard curve.
2.8.2. Determination of IL-6 and TNF-α
The IL-6 and TNF-α produced by macrophages treated with live/heat-killed L. coryniformis NA-3 was determined by the enzyme-linked immunosorbent assay (ELISA) method. We used ELISA Max™ Deluxe kits (BioLegend, San Diego, CA, USA), according to the manufacturer’s instructions.
2.8.3. Proliferation
After collecting cell supernatant (Section 2.8.1), the MTS method was used for proliferation determination as described in Section 2.7.
2.8.4. Intracellular Reactive Oxygen Species Measurement
ROS production in macrophages was quantified by the fluorescence spectrophotometry method described in our previous study [29]. A fluorescence intensity of 485/528 nm in each well was measured using a Synergy H1 microplate reader (BioTek, Winooski, VT, USA). The fluorescence intensity increased with the production of ROS. The result was calculated using the F485/528 result as follows:
ROS% = (The value of sample)/(The value of negative control) × 100%
2.8.5. The Expression of the iNOS of Macrophages Treated with Live and Heat-Killed L. coryniformis NA-3
RAW 264.7 macrophages (500,000 cells/well) were seeded in 6-well plates and grown overnight. The cells were treated with 107 CFU/mL of live/ heat-killed L. coryniformis NA-3 and 108 CFU/mL of heat-killed L. coryniformis NA-3 for 24 h. Treatment with LPS (1 μg/mL) was regarded as the positive control, and cells grown in DMEM medium with 10% FBS were the negative control.
Western Blot
After being treated for 24 h, the whole cell lysate was extracted, and Western blotting was performed according to our previous study [29]. The band intensity was quantitatively analyzed using ImageJ.
2.9. Statistical Analysis
Experiments were conducted at least in triplicate, and the results are presented as mean ± standard deviation. All statistical significances were analyzed using IBM SPSS Statistics Version 26 (IBM, Armonk, NY, USA). The data were evaluated with one-way ANOVA and compared using Duncan’s test. p < 0.05 was regarded as statistically significant.
3. Results and Discussion
3.1. Result of Antibiotic Susceptibility
Table 2 shows that L. coryniformis NA-3 was resistant to four antibiotics: oxacillin, imipenem, vancomycin and norfloxacin. The judgment standard of minocycline, azithromycin, lincomycin and florfenicol is not referred to at present. Although they had significant inhibition zones, they could not be defined. Another three antibiotics (ceftriaxone, kanamycin and ciprofloxacin) exhibited medium susceptibility for L. coryniformis NA-3. The other 19 antibiotics expressed sensibility for L. coryniformis NA-3. Antibiotic resistance genes can be transferred to other bacteria by conjugating plasmids and transposons [31]. It is hazardous to deliver antibiotic resistance genes to other microorganisms, especially pathogenic bacteria. Moreover, a sensitivity analysis of LAB is important when prescribing probiotic therapy against the background of the use of antibiotics. Our results suggest that L. coryniformis NA-3 cannot be used for therapy when most antibiotics are used, except for oxacillin, imipenem, vancomycin and norfloxacin. Reports suggest that Latilactobacillus is always sensitive to some antibiotics when used as a probiotic. William P Charteris reported that L. acidophilus, L. casei, L. rhamnosus, L. reuteri and L. fermentum were all sensitive to tetracycline, chloramphenicol, erythromycin and clindamycin when using the disc diffusion method [24]. These are similar to the results for L. coryniformis NA-3. However, Latilactobacillus does not exhibit broad-spectrum susceptibility to antibiotics. After being assessed via the disk diffusion test, L. fermentum, L. crispatus, L. plantarum and L. jensenii were mostly resistant to quinolones and showed moderate sensitivity to some other antibiotics [23]. The properties of L. coryniformis NA-3 are similar to those of Latilactobacillus as described in the literature, i.e., it expresses sensitivity to most antibiotics.

Table 2.
Inhibition zone diameter (mm) and susceptibility results of antibiotics against Loigolactobacillus coryniformis NA-3.
3.2. Probiotic Properties of L. coryniformis NA-3
3.2.1. Antibacterial Result
The survival rates of B. cereus, S. typhimurium, E. coli O157:H7 and S. aureus after being cocultured with L. coryniformis NA-3 are shown in Figure 1. B. cereus had the highest survival rate of 1.34% at 24 h and 0.31% at 48 h. The survival rate of S. typhimurium (0.35%) was less than that of B. cereus (1.34%) at 24 h. After 48 h, S. typhimurium was undetectable; however, 0.31% of the B. cereus survived. E. coli O157:H7 and S. aureus were almost all dead at 24 h. These results suggest that E. coli O157:H7 and S. aureus were sensitive to L. coryniformis NA-3, and S. typhimurium was also sensitive to it but to a lesser extent. B. cereus exhibited some resistance to L. coryniformis NA-3. The supernatant of L. coryniformis NA-3 also exhibited antibacterial capacity in the four pathogenic bacteria, as Figure 2 shows. Generally, the antibacterial activity of probiotics should be confirmed under the condition of coexist for probiotic and pathogenic bacteria. Coculture is a means of determining the viability of microorganisms grown with other organisms. The results of cocultivation directly suggest that L. coryniformis NA-3 shows antibacterial activity. LAB generally show antibacterial activity, mostly due to their metabolites, such as organic acid (mostly lactic acid), bacteriocin and hydrogen peroxide. The antibacterial ability of metabolites is always evaluated with the supernatant of a bacterial suspension. The bacteriostatic circle method is commonly used to determine the antimicrobial activity of potential probiotics. L. coryniformis NA-3 supernatant showed no effect on the pathogenic bacteria after neutralization with alkali (Figure 2), and MRS broth supplemented with acid showed an obvious inhibition circle, suggesting that organic acid may be the main antimicrobial substance in the metabolites of L. coryniformis NA-3. The fermentation supernatant of L. plantarum zrx03 isolated from an infant’s feces strongly inhibited E. coli JM109, S. aureus and Listeria monocytogenes, and the inhibition zone was significantly observed [32]. The supernatant of L. coryniformis NA-3 acted on B. cereus, S. Typhimurium, E. coli O157:H7 and S. aureus, which showed similar inhibition zones, suggesting good antibacterial activity similar to that of L. plantarum zrx03.

Figure 1.
The survival rate of the four pathogenic bacteria (B. cereus, S. typhimurium, E. coli O157:H7, S. aureus) after being cocultured with Loigolactobacillus coryniformis NA-3 for 24 h and 48 h. Different lowercase letters mean significant differences (p < 0.05).

Figure 2.
Antibacterial result of Loigolactobacillus coryniformis NA-3 supernatant evaluated by Oxford cup test. (a) B. cereus. (b) S. Typhimurium. (c) E. coli O157:H7. (d) S. aureus. 1: Original supernatant of L. coryniformis NA-3 (pH 4.0). 2: Supernatant of L. coryniformis NA-3 with pH adjusted to 7.0. 3: Original MRS broth (pH 6.0). 4: MRS broth with pH adjusted to 4.0.
3.2.2. Cholesterol Removal and BSH Production Ability
The production of BSH is one of the assessment standards for probiotics. Bile salts can be decomposed into amino acids and cholic acids by BSH. A white precipitate is produced after cholic acids react with cholesterol. Thus, BSH-producing probiotics are helpful for cholesterol removal. White sediment appeared when L. coryniformis NA-3 was grown on a medium supplemented with cholesterol (Figure 3a). This phenomenon means that a reaction between cholic acid and cholesterol occurred, suggesting the production of BSH. The color reaction of white sediment and ninhydrin was obviously bluish-violet and darker than ninhydrin solution and MRS broth (Figure 3b), indicating enzyme production. It has been demonstrated that elevated serum cholesterol levels increase the risk of atherosclerosis and coronary heart disease [33]. Cholesterol removal is always used as an evaluation criterion for probiotics. Bile salt metabolism and cholesterol metabolism are closely related. Deconjugated bile salts by BSH are able to co-precipitate cholesterol at low pH levels, which is an effective in vitro experiment to expose the role of the BSH activity of Latilactobacilli in relation to cholesterol lowering in culture liquid [33]. L. casei ASCC 292 has been reported to exhibit cholesterol removal activity [34]. For L. coryniformis NA-3, similar results to L. casei ASCC 292 were observed. In addition, the ninhydrin reaction is a method for determining the production of enzymes. Results involving white sediment and color reactions suggest the cholesterol removal ability and BSH production of L. coryniformis NA-3.
Figure 3.
Result of cholesterol removal and bile salt hydrolase production of Loigolactobacillus coryniformis NA-3. (a) White sediment appeared when L. coryniformis NA-3 was grown on a medium supplemented with cholesterol. (b) The color reaction of white sediment and ninhydrin was obviously bluish-violet and darker than ninhydrin solution and MRS broth, indicating enzyme production.
3.3. Observation of Live and Heat-Killed Strains
The cells of viable and heat-killed L. coryniformis NA-3 were observed with SEM, and the images are shown in Figure 4. L. coryniformis NA-3 was short and rod-shaped, presenting the typical characteristics of lactobacilli. Wirelike objects were attached to the surface of viable L. coryniformis NA-3 (Figure 4a). The attachments were significantly reduced after thermal killing, and they almost disappeared (Figure 4b). However, the integral morphology was not destroyed following heat treatment. Host–microbial interactions are complex molecular mechanisms. When bacteria arrive, host immune cells recognize the conserved microbial components, called “microbial–associated molecular patterns (MAMPs)”, through germline-encoded pattern recognition receptors (PRRs), activating innate defense mechanisms [35]. There are some MAMPs on the surface of probiotics, including lipopolysaccharide (LPS), peptidoglycan (PG), lipoteichoic acid (LTA), lipoprotein (LP) and others, which can specifically bind to Toll–like receptors–2 (TLR2) on intestinal cells [35]. As the images show, the cell wall of heat-killed L. coryniformis NA-3 maintained its original dimensional morphology. There were reserved active substances in cell walls, similar to viable bacteria, which may lead to the preservation of some of the biological functions of living L. coryniformis NA-3 cells in heat-killed cells.

Figure 4.
Micromorphology of live (a) and heat-killed (b) Loigolactobacillus coryniformis NA-3.
3.4. Antioxidant Activity
The antioxidant activity of live and heat-killed L. coryniformis NA-3 was evaluated by scavenging free radicals, as Figure 5 shows, including ABTS, DPPH, NO, hydroxyl radical, and superoxide radical. The results suggest that both live and heat-killed L. coryniformis NA-3 exhibited various scavenging capacities for different free radicals. Viable L. coryniformis NA-3 almost did not work on NO; however, heat-killed cells could scavenge a bit of NO (5%), showing better activity than live cells. L. coryniformis NA-3 can significantly scavenge the free radicals of ABTS, DPPH, hydroxyl radical and superoxide radicals. The scavenging ratio of heat-killed L. coryniformis NA-3 (58%) was also about 12% higher than that of viable cells (46%) on ABTS. Untreated L. coryniformis NA-3 was more active than heated cells when scavenging DPPH (45%), hydroxyl radicals (23%) and superoxide radicals (29%). Nonetheless, heat-killed cells also had different effects on scavenging DPPH (32%), hydroxyl radicals (20%) and superoxide radicals (27%), to varying degrees. In conclusion, L. coryniformis NA-3 shows antioxidant activity and can also maintain this capacity after thermal treatment. Heat-killed L. coryniformis NA-3 may be even better than live cells at radical scavenging in some instances.

Figure 5.
Antioxidant activity of live and heat-killed Loigolactobacillus coryniformis NA-3 evaluated by scavenging free radicals. Different lowercase letters mean significant differences (p < 0.05).
It is known that antioxidative compounds on the cell surface are mostly proteins, exopolysaccharides and lipoteichoic acid. Antioxidant enzymes, bioactive peptides and manganese ions that exist in LAB cells also influence their antioxidant effects [11]. A previous study found that the intact cells of L. plantarum MA2 possessed a higher radical scavenging capacity than the culture supernatant and cell–free extract [9]. DPPH and ABTS scavenging activities are generally used to evaluate the antioxidant properties of live or killed lactobacillus. Seo-Jin Yang et al. [11] reported that viable L. plantarum 200655 can scavenge 32% of DPPH and 38% of ABTS free radicals. The live L. coryniformis NA-3 used in our study had higher scavenging activity on DPPH (45%) and ABTS (46%) than the reported L. plantarum 200655. Additionally, live/heat-killed L. plantarum Ln1 from Kimchi and L. plantarum KCTC 3108 were also effective at scavenging DPPH and ABTS [13]. For DPPH, L. coryniformis NA-3 (both live and heat-killed cells) showed higher scavenging activity than Ln1 and KCTC 3108. L. coryniformis NA-3 was weaker than Ln1 and KCTC 3108 at ABTS scavenging. In contrast, heat-killed L. coryniformis NA-3 was significantly better than live L. coryniformis NA-3 when it came to ABTS scavenging, which is different from the reported Ln1 and KCTC 3108. Additionally, our results also suggest that live and heat-killed L. coryniformis NA-3 exhibited NO, hydroxyl radical and superoxide free radical scavenging activities and that heat-killed cells in particular were more effective than live L. coryniformis NA-3 when it came to NO scavenging.
3.5. Anticancer Activity
The anticancer activity of live and heat-killed L. coryniformis NA-3 was assessed using colon cancer cell HT-29 (Figure 6). The proliferation of HT-29 cells treated with heat-inactivated L. coryniformis NA-3 was not significantly different from the negative control, indicating no effect on the growth of cancer cells. Live L. coryniformis NA-3 cells obviously inhibited the proliferation of HT-29 cells with dose dependency. Cells grown with 106 CFU/mL L. coryniformis NA-3 were all ineffective at the inhibition of HT-29 cell growth. The proliferation of cancer cells treated with 107 CFU/mL (85%) live L. coryniformis NA-3 was significantly decreased when compared with untreated HT-29 cells (100%). HT-29 cells almost could not grow at all when cultivated with 108 CFU/mL of live L. coryniformis NA-3. These results indicate that inactive L. coryniformis NA-3 has no inhibitory activity on the growth of cancer cells; however, live bacteria are effective. In vitro studies have demonstrated that live cells of probiotics possess higher antimutagenic activity by improving the host’s immune response, altering the metabolic activity of the intestinal microbiota, binding and degrading carcinogens, producing antimutagenic compounds and altering the physiochemical conditions in the colon [36]. Our results revealed that live L. coryniformis NA-3 was effective in terms of its anticancer effects, which may be attributed to some metabolites secreted from the viable strains. The reason that heat-killed L. coryniformis NA-3 cells were not effective in terms of cancer cell proliferation may be their inability to produce anticancer metabolites. It is reasonable to suppose that the metabolites of L. coryniformis NA-3 play an important role in its anticancer activity. However, multiple factors may be involved.

Figure 6.
The anticancer activity of live and heat-killed Loigolactobacillus coryniformis NA-3 as evaluated using HT-29 cells. CK: Macrophages without treatment. Numbers 6, 7 and 8 on the abscissa: macrophages treated with different bacteria counts of Log CFU. Different lowercase letters mean significant differences (p < 0.05).
3.6. Immunoregulation Activity
3.6.1. Proliferation
A quantitative assay of proliferation was conducted using the MTS method, and the results are exhibited in Figure 7a. Compared to the untreated cells (100%), the proliferation of LPS-treated macrophages was promoted. L. coryniformis NA-3 showed dose-dependent cytotoxicity on macrophages, especially live strains. The proliferation of cells treated with 106 CFU/mL of viable and heat-killed L. coryniformis NA-3 showed no significant difference when compared with the negative control (100%), indicating no cytotoxicity. The survivability of macrophages cocultured with 107 CFU/mL live and heat-killed L. coryniformis NA-3 was 70% and 72%, showing no significant difference. L. coryniformis NA-3 at 108 CFU/mL expressed serious cytotoxicity due to the proliferation of macrophages. The survivability of macrophages treated with 108 CFU/mL of viable L. coryniformis NA-3 was only 23%. This value was 43% for the heated samples. Heat-killed L. coryniformis NA-3 had less of an impact than live samples at 108 CFU/mL. The proliferation of treatments with 107~108 CFU/mL of samples demonstrated that heat-killed L. coryniformis NA-3 was less detrimental to cell reproduction than live samples and had higher security. A previous report showed that RAW 264.7 cell viability decreased as the concentration of L. rhamnosus GG and L. brevis KCCM 12203P increased. Additionally, viable L. rhamnosus GG and L. brevis KCCM 12203P exhibited lower cell viability than heat-killed cells, which is a similar result to that of our study [27].

Figure 7.
Results of proliferation (a), NO (b), IL-6 (c), TNF-α (d), ROS (e), and iNOS expression (f) of RAW 264.7 macrophages treated with live and heat-killed Loigolactobacillus coryniformis NA-3. Different lowercase letters mean significant differences (p < 0.05). CK: macrophages without treatment. LPS: macrophages treated with LPS (1 μg/mL). Numbers 6, 7 and 8 on the abscissa: macrophages treated with different bacteria counts of Log CFU.
3.6.2. Production of NO and Cytokines (IL-6 and TNF-α)
A NO assay performed on RAW 264.7 cells was used to evaluate the immune-modulating properties of live and heat-killed L. coryniformis NA-3 in vitro (Figure 7b). Both viable and heat-killed samples can induce NO expression in macrophages. For L. coryniformis NA-3, the untreated and heat-killed cells were insufficient at 106 CFU/mL to induce NO production. When strains were increased to 107~108 CFU/mL, NO was dramatically improved. The treatment groups of live L. coryniformis NA-3 produced 7.2 μM and 13.8 μM of NO at 107 CFU/mL and 108 CFU/mL, respectively. The production of macrophages induced by 107 CFU/mL and 108 CFU/mL of heat-killed L. coryniformis NA-3 were 3.4 μM and 12.7 μM NO, respectively, which are less than the values for viable cells. When the dosage of L. coryniformis NA-3 was increased to 108 CFU/mL, the different effects of live and heat-killed samples decreased markedly. The data show that heat-treated L. coryniformis NA-3 also had significant immune-regulation properties that are similar to those of viable strains. It has been reported that live lactobacillus possesses immunomodulation characteristics. For example, L. plantarum 200655 isolated from cabbage kimchi enhanced immunity in RAW 264.7 cells by promoting the production of NO and cytokines [10]. Heat-killed L. plantarum emerged as a potentially important modulator of immune response, just as L. plantarum LM1004 enhances early innate immunity by activating macrophages via the TLR-2/MAPK/NF-κB signaling pathway [20]. The moderate release of NO in organisms can cause many physiological effects, such as promoting the activity of natural killer (NK) cells, activating peripheral blood mononuclear cells and regulating T lymphocytes. The excessive or insufficient production of NO produces a series of pathological effects that harm human health, e.g., by destroying DNA and some synthetases. Though NO performs a pivotal role as an immune regulator in a variety of tissues [37], it should be kept within appropriate limits. In this study, we demonstrated that L. coryniformis NA-3 was an effective strain for the NO production of macrophages, suggesting the potential stimulation of immunoregulation. Viable bacteria proliferation may be the main reason causing higher NO production when compared with heat-killed strains. Considering the safety evaluation, heat-killed probiotics may be a better immune activator for applications.
To survey the effect of live and heat-killed L. coryniformis NA-3 on immunoregulation, the production of IL-6 and TNF-α was also evaluated using ELISA. IL-6 and TNF-α were stimulated after cell exposure to live and heat-killed L. coryniformis NA-3. The production of IL-6 (Figure 7c) in the untreated RAW 264.6 cells was almost 0 pg/mL, whereas the cell supernatant cocultured with 1 μg/mL LPS was measured at 693~768 pg/mL. IL-6 in the cell culture that included heat-treated L. coryniformis NA-3 at 107 CFU/mL and live strains at 108 CFU/mL was almost undetectable, and no significant differences were detected between them and the negative group (0 pg/mL). However, the stimulation of IL-6 was increased to around 90 pg/mL after being co-induced with 107 CFU/mL live samples. Furthermore, IL-6 in cell supernatant treated with heat-killed L. coryniformis NA-3 at 108 CFU/mL was approximately 200 pg/mL lower than that of the LPS-stimulated group, which is an acknowledged immunomodulator activator. TNF-α production induced by different samples is illustrated in Figure 7d. Untreated RAW 264.7 macrophages and cells treated with 108 CFU/mL of live L. coryniformis NA-3 almost did not secrete TNF-α. The production of TNF-α in cell supernatant co-stimulated with 107 CFU/mL live L. coryniformis NA-3 was 138 pg/mL, which is obviously more than that observed in the heated strains (61 pg/mL). Heat-treated samples at 108 CFU/mL expressed a stronger capacity for TNF-α induction (271 pg/mL) which was even significantly higher than the LPS control (155~190 pg/mL). Above all, both live and heat-killed L. coryniformis NA-3 revealed the stimulation of proinflammatory cytokines, suggesting immunoregulatory activity. Less production of IL-6 and TNF-α in live 108 CFU/mL L. coryniformis NA-3 may be mostly due to its toxicity for cell proliferation. IL-6 and TNF-α are two major cytokines secreted by activated macrophages. These results suggest that L. coryniformis NA-3 promotes immunoregulatory effects via stimulating macrophages.
Macrophages are immune cells that play a crucial part in innate and adaptive immune responses. When macrophages are activated, they can produce NO to kill antigens and secrete cytokines such as IL-6 and TNF-α to activate specific immune responses. Many live and heat-killed lactobacilli have been reported to possess immune-enhancing activity by inducing NO and modulatory cytokine profiles in macrophages. For instance, Lactobacillus fermentum DLBSA204 can activate macrophage cells by improving NO and cytokine expression levels [38]. Live and heat-killed L. rhamnosus ATCC 7469 were effective at producing IL-6 and TNF-α in macrophage culture supernatants, suggesting the positive activity of strain L. rhamnosus ATCC 7469 in the modulation or in stimulation of immune responses [39]. The TNF-α production by macrophages cocultured with live L. rhamnosus ATCC 7469 is higher than that in heat-killed cells, which is consistent with L. coryniformis NA-3. IL-6 production is higher in macrophages after treatment with heat-killed L. rhamnosus ATCC 7469 when compared with live cells, which is similar to the result of 108 CFU/mL of live and heat-killed L. coryniformis NA-3. NO, IL-6 and TNF-α were also effectively induced when macrophages were treated with both live and heat-inactivated L. casei and L. plantarum cells [40]. For different LAB, live and heat-killed strains show various activities when it comes to inducing NO and cytokines. Our results suggest that live L. coryniformis NA-3 has a better ability to secrete NO and cytokines (IL-6 and TNF-α). However, 108 CFU/mL of live L. coryniformis NA-3 greatly inhibited cell proliferation, which is not a beneficial phenomenon. When considering cell cytotoxicity, heat-killed LAB may be safer for further applications.
3.6.3. Reactive Oxygen Species
As Figure 7e shows, intracellular ROS in macrophages could be induced by L. coryniformis NA-3. It exhibited no significant differences in ROS production at 106 CFU/mL with untreated cells. However, live L. coryniformis NA-3 expressed a little more potential than the heat-killed treatment. With an increase in dosage, the ROS production of cells treated with 107 CFU/mL of live and inviable strains rises, especially for viable bacteria, showing better effect than LPS. At a dose of 108 CFU/mL, cells treated with live strains only produce rare ROS, mostly due to cell cytotoxicity. However, 108 CFU/mL of inactivated strains could also stimulate ROS production in macrophages that was almost not significantly different from LPS treatment. The ROS production of macrophages treated with live and heat-killed L. coryniformis NA-3 was significantly different. Live L. coryniformis NA-3 can grow and produce metabolites, but heat-killed strains cannot. It is reasonable to speculate that the mechanism for ROS production may be different for live and heat-killed L. coryniformis NA-3. Regardless, both live and heat-inactivated L. coryniformis NA-3 possessed the ability to induce ROS production. High concentration of ROS may lead to non-specific damage to proteins, lipids and nucleic acids, increasing the risk of cardiovascular disease, neurological disorders, cancers and chronic inflammation [41]. Additionally, ROS also play a critical role in various biological functions, including cell survival, cell growth, proliferation and differentiation and immune response [42]. Clearly, 106~108 CFU/mL of live L. coryniformis NA-3 and 107~108 CFU/mL of heat-treated strains have potential immune regulation activity via the inducing of the production of ROS. However, more ROS were generated by macrophages treated with live Latilactobacillus than those treated with inactivated samples at the same dose. In consideration of the risk to health of excessive ROS, heat-killed L. coryniformis NA-3 may be more suitable for use for immunoregulation.
3.6.4. Expression of iNOS
Figure 7f shows the result of iNOS expression. Induced nitric oxide synthase (iNOS) expression was examined based on the production of NO (Figure 7a) generated by RAW 264.7 cells. L. coryniformis NA-3 enhanced the iNOS expression in macrophages both with and without heat treatment. Compared to LPS (1 μg/mL), 107 CFU/mL of live L. coryniformis NA-3 significantly promoted iNOS production. However, the heat-killed strain was slightly weaker than live L. coryniformis NA-3. Three nitric oxide synthase (NOS) isozymes are responsible for NO production, including endothelial NOS (eNOS), neural NOS and inducible Ca2+/NOS (iNOS) [43]. The former two are Ca2+-dependent and are expressed constitutively (cNOS). The iNOS expression is Ca2+-independent and can provide a high output of NO generation for host defense, once induced [44]. Because NO is induced through the oxidation of L-arginine by iNOS, the production of iNOS cocultured with LAB strains showed similar results to NO production [11]. Previous reports have shown that L. rhamnosus GG, L. plantarum 200655 and L. plantarum KCTC 3108 all induced the expression of iNOS, which is consistent with the NO production and exerts immune-enhancing effects by stimulating macrophages [11]. Similar to the reported LAB (L. rhamnosus GG, L. plantarum 200655 and L. plantarum KCTC 3108), L. coryniformis NA-3 can also promote the NO production of macrophages via the NO/iNOS signal pathway and participate in the process of immune regulation.
4. Conclusions
L. coryniformis NA-3 isolated from Chinese sauerkraut showed susceptibility to most antibiotics, together with antibacterial and cholesterol removal properties. In addition, heat-killed L. coryniformis NA-3 also exhibited antioxidant and immunity-stimulation characteristics similar to those of live strains, which is promising for applications in functional food and the pharmaceutical industry as a safer potential probiotic and immuno-stimulating ingredient.
Author Contributions
Conceptualization, B.S. and X.X.; methodology, X.X.; software, X.X.; validation, B.S., Y.Q. and X.X.; formal analysis, X.X.; investigation, Y.Q. and Q.P.; resources, Q.P.; data curation, X.X.; writing—original draft preparation, X.X.; writing—review and editing, X.X. and B.S.; visualization, X.X.; supervision, B.S.; project administration, B.S. All authors have read and agreed to the published version of the manuscript.
Funding
This research was supported by Beijing Natural Science Foundation, grant number 6232039.
Data Availability Statement
All methods and related data are presented in this paper. Additional inquiries should be addressed to the corresponding author.
Conflicts of Interest
The authors declare no conflict of interest.
References
- Garbacz, K. Anticancer activity of lactic acid bacteria. Semin. Cancer Biol. 2022, 86, 356–366. [Google Scholar] [CrossRef] [PubMed]
- Reuben, R.C.; Roy, P.C.; Sarkar, S.L.; Alam, R.-U.; Jahid, I.K. Isolation, characterization, and assessment of lactic acid bacteria toward their selection as poultry probiotics. BMC Microbiol. 2019, 19, 253. [Google Scholar] [CrossRef] [PubMed]
- Lübeck, M.; Lübeck, P.S. Application of lactic acid bacteria in green biorefineries. FEMS Microbiol. Lett. 2019, 366, fnz024. [Google Scholar] [CrossRef]
- Seon-Kyun, K.; Robin, B.G.; You-Tae, K.; Joongi, K.; Hyeri, K.; Hyoung, C.J.; Bum, K.H.; Ju-Hoon, L. Role of Probiotics in Human Gut Microbiome-Associated Diseases. J. Microbiol. Biotechnol. 2019, 29, 1335–1340. [Google Scholar]
- Fan, S.; Xue, T.; Bai, B.; Bo, T.; Zhang, J. Probiotic Properties Including the Antioxidant and Hypoglycemic Ability of Lactic Acid Bacteria from Fermented Grains of Chinese Baijiu. Foods 2022, 11, 3476. [Google Scholar] [CrossRef]
- Yadav, R.; Singh, P.K.; Puniya, A.K.; Shukla, P. Catalytic interactions and molecular docking of bile salt hydrolase (BSH) from L. plantarum RYPR1 and its prebiotic utilization. Front. Microbiol. 2016, 7, 2116. [Google Scholar] [CrossRef]
- Yadav, M.; Dixit, M.; Shukla, P. Probiotics of diverse origin and their therapeutic applications: A review. J. Am. Coll. Nutr. 2020, 39, 469–479. [Google Scholar] [CrossRef] [PubMed]
- Al-Shehri, S.S. Reactive oxygen and nitrogen species and innate immune response. Biochimie 2021, 181, 52–64. [Google Scholar] [CrossRef] [PubMed]
- Tang, W.; Xing, Z.; Li, C.; Wang, J.; Wang, Y. Molecular mechanisms and in vitro antioxidant effects of Lactobacillus plantarum MA2. Food Chem. 2017, 221, 1642–1649. [Google Scholar] [CrossRef] [PubMed]
- Mishra, V.; Shah, C.; Mokashe, N.; Chavan, R.; Yadav, H.; Prajapati, J. Probiotics as potential antioxidants: A systematic Review. J. Agric. Food Chem. 2015, 63, 3615–3626. [Google Scholar] [CrossRef]
- Yang, S.-J.; Lee, J.-E.; Lim, S.-M.; Kim, Y.-J.; Lee, N.-K.; Paik, H.-D. Antioxidant and immune-enhancing effects of probiotic Lactobacillus plantarum 200655 isolated from kimchi. Food Sci. Biotechnol. 2019, 28, 491–499. [Google Scholar] [CrossRef] [PubMed]
- Lin, M.Y.; Chang, F.J. Antioxidative effect of intestinal bacteria Bifidobacterium longum ATCC 15708 and Lactobacillus acidophilus ATCC 4356. Dig. Dis. Sci. 2000, 45, 1617–1622. [Google Scholar] [CrossRef] [PubMed]
- Jang, H.J.; Song, M.W.; Lee, N.K.; Paik, H.D. Antioxidant effects of live and heat-killed probiotic Lactobacillus plantarum Ln1 isolated from kimchi. J. Food Sci. Technol. 2018, 55, 3174–3180. [Google Scholar] [CrossRef]
- Zhang, N.; Li, C.; Niu, Z.; Kang, H.; Wang, M.; Zhang, B.; Tian, H. Colonization and immunoregulation of Lactobacillus plantarum BF_15, a novel probiotic strain from the feces of breast-fed infants. Food Funct. 2020, 11, 3156–3166. [Google Scholar] [CrossRef] [PubMed]
- Marteau, P.; Pochart, P.; Flourié, B.; Pellier, P.; Santos, L.; Desjeux, J.F.; Rambaud, J.C. Effect of chronic ingestion of a fermented dairy product containing Lactobacillus acidophilus and Bifidobacterium bifidum on metabolic activities of the colonic flora in humans. Am. J. Clin. Nutr. 1990, 52, 685–688. [Google Scholar] [CrossRef] [PubMed]
- Stoner, G.D.; Mukhtar, H. Polyphenols as cancer chemopreventive agents. J. Cell. Biochem. 1995, 59, 169–180. [Google Scholar] [CrossRef] [PubMed]
- Castillo, N.A.; Perdigon, G.; de Moreno, D.L.A. Oral administration of a probiotic Lactobacillus modulates cytokine production and TLR expression improving the immune response against Salmonella enterica serovar Typhimurium infection in mice. BMC Microbiol. 2011, 11, 177. [Google Scholar] [CrossRef] [PubMed]
- Wolf, A.J.; Underhill, D.M. Peptidoglycan recognition by the innate immune system. Nat. Rev. Immunol. 2018, 18, 243–254. [Google Scholar] [CrossRef]
- Adams, C.A. The probiotic paradox: Live and dead cells are biological response modifiers. Nutr. Res. Rev. 2010, 23, 37–46. [Google Scholar] [CrossRef] [PubMed]
- Lee, J.; Jung, I.; Choi, J.W.; Lee, C.W.; Cho, S.; Choi, T.G.; Sohn, M.; Park, Y.I. Micronized and heat-treated Lactobacillus plantarum LM1004 stimulates host immune responses via the TLR-2/MAPK/NF-κB signalling pathway in vitro and in vivo. J. Microbiol. Biotechnol. 2019, 29, 704–712. [Google Scholar] [CrossRef]
- Xu, X.; Peng, Q.; Zhang, Y.; Tian, D.; Zhang, P.; Huang, Y.; Ma, L.; Qiao, Y.; Shi, B. A novel exopolysaccharide produced by Lactobacillus coryniformis NA-3 exhibits antioxidant and biofilm-inhibiting properties in vitro. Food Nutr. Res. 2020, 64, 3744. [Google Scholar] [CrossRef] [PubMed]
- Tendencia, E.A. Disk diffusion method. In Laboratory Manual of Standardized Methods for Antimicrobial Sensitivity Tests for Bacteria Isolated from Aquatic Animals and Environment; Aquaculture Department, Southeast Asian Fisheries Development Center: Tigbauan, Philippines, 2004; pp. 13–29. [Google Scholar]
- Xu, H.; Tian, W.; Jia, L.; Cheng, B.; Ming, Z. Antibiotic susceptibility of potential probiotic lactobacilli isolated from the vagina of Chinese pregnant women. In Proceedings of the 2008 International Conference on BioMedical Engineering and Informatics (BMEI 2008), Sanya, China, 28–30 May 2008; Volume 2. [Google Scholar]
- Charteris, W.P.; Kelly, P.M.; Morelli, L.; Collins, J.K. Antibiotic susceptibility of potentially probiotic lactobacillus species. J. Food Prot. 1999, 61, 1636–1643. [Google Scholar] [CrossRef] [PubMed]
- Xu, X.; Peng, Q.; Zhang, Y.; Tian, D.; Zhang, P.; Huang, Y.; Ma, L.; Dia, V.; Qiao, Y.; Shi, B. Antibacterial potential of a novel Lactobacillus casei strain isolated from Chinese northeast sauerkraut and the antibiofilm activity of its exopolysaccharides. Food Funct. 2020, 11, 4697–4706. [Google Scholar] [CrossRef] [PubMed]
- Rocha-Ramírez, L.M.; Hernández-Ochoa, B.; Gómez-Manzo, S.; Marcial-Quino, J.; Cárdenas-Rodríguez, N.; Centeno-Leija, S.; García-Garibay, M. Evaluation of immunomodulatory activities of the heat-Killed probiotic strain Lactobacillus casei IMAU60214 on macrophages in vitro. Microorganisms 2020, 8, 79. [Google Scholar] [CrossRef] [PubMed]
- Song, M.W.; Jang, H.J.; Kim, K.-T.; Paik, H.-D. Probiotic and antioxidant properties of novel Lactobacillus brevis KCCM 12203P isolated from kimchi and evaluation of immune-stimulating activities of its heat-killed cells in RAW 264.7 cells. J. Microbiol. Biotechnol. 2019, 29, 1894–1903. [Google Scholar] [CrossRef] [PubMed]
- Tsai, P.-J.; Tsai, T.-H.; Yu, C.-H.; Ho, S.-C. Comparison of NO-scavenging and NO-suppressing activities of different herbal teas with those of green tea. Food Chem. 2007, 103, 181–187. [Google Scholar] [CrossRef]
- Xu, X.; Qiao, Y.; Peng, Q.; Shi, B.; Dia, V.P. Antioxidant and immunomodulatory properties of partially purified exopolysaccharide from Lactobacillus casei Isolated from Chinese Northeast sauerkraut. Immnological Investig. 2022, 51, 748–765. [Google Scholar] [CrossRef]
- Xu, X.; Qiao, Y.; Shi, B.; Dia, V.P. Alcalase and bromelain hydrolysis affected physicochemical and functional properties and biological activities of legume proteins. Food Struct. 2021, 27, 100178. [Google Scholar] [CrossRef]
- Teuber, M.; Meile, L.; Schwarz, F. Acquired antibiotic resistance in lactic acid bacteria from food. Antonie Van Leeuwenhoek 1999, 76, 115–137. [Google Scholar] [CrossRef]
- Lei, S.; Zhao, R.; Sun, J.; Ran, J.; Ruan, X.; Zhu, Y. Partial purification and characterization of a broad-spectrum bacteriocin produced by a Lactobacillus plantarum zrx03 isolated from infant’s feces. Food Sci. Nutr. 2020, 8, 2214–2222. [Google Scholar] [CrossRef]
- Smet, I.D.; Hoorde, L.V.; Saeyer, N.D.; Woestyne, M.V.; Verstraete, W. In vitro study of bile salt hydrolase (BSH) activity of BSH isogenic Lactobacillus plantarum 80 strains and estimation of cholesterol lowering through enhanced BSH activity. Microb. Ecol. Health Dis. 1994, 7, 315–329. [Google Scholar]
- Liong, T.M.; Shah, P.N. Optimization of cholesterol removal by probiotics in the presence of prebiotics by using a response surface method. Appl. Environ. Microbiol. 2005, 71, 1745–1753. [Google Scholar] [CrossRef] [PubMed]
- Sukhithasri, V.; Nisha, N.; Biswas, L.; Kumar, V.A.; Biswas, R. Innate immune recognition of microbial cell wall components and microbial strategies to evade such recognitions. Microbiol. Res. 2013, 168, 396–406. [Google Scholar] [CrossRef] [PubMed]
- Kumar, M.; Kumar, A.; Nagpal, R.; Mohania, D.; Behare, P.; Verma, V.; Kumar, P.; Poddar, D.; Aggarwal, P.K.; Henry, C.J.; et al. Cancer-preventing attributes of probiotics: An update. Int. J. Food Sci. Nutr. 2010, 61, 473–496. [Google Scholar] [CrossRef] [PubMed]
- Amin, A.R.; Attur, M.; Abramson, S.B. Nitric oxide synthase and cyclooxygenases: Distribution, regulation, and intervention in arthritis. Curr. Opin. Rheumatol. 1999, 11, 202. [Google Scholar] [CrossRef] [PubMed]
- Wulandari, A.; Tandrasasmita, O.; Tjandrawinata, R. Immunomodulatory and macrophage activating activity of Lactobacillus fermentum DLBSA204 in response to respiratory infection in a cellular model. Biosci. Biotechnol. Res. Asia 2016, 13, 1291–1302. [Google Scholar] [CrossRef]
- Jorjao, A.L.; de Oliveira, F.E.; Leao, M.V.; Carvalho, C.A.; Jorge, A.O.; de Oliveira, L.D. Live and heat-Killed Lactobacillus rhamnosus ATCC 7469 may induce modulatory cytokines profiles on macrophages RAW 264.7. Sci. World J. 2015, 2015, 716749. [Google Scholar] [CrossRef]
- Chen-Kai, C.; Shu-Chen, W.; Chih-Kwang, C.; Shih-Ying, C.; Zong-Tsi, C.; Pin-Der, D. Effect of lactic acid bacteria isolated from fermented mustard on immunopotentiating activity. Asian Pac. J. Trop. Biomed. 2015, 5, 281–286. [Google Scholar]
- Brieger, K.; Schiavone, S.; Miller, F.J., Jr.; Krause, K.H. Reactive oxygen species: From health to disease. Swiss Med. Wkly. 2012, 142, w13659. [Google Scholar] [CrossRef] [PubMed]
- Yang, Y.; Bazhin, A.V.; Werner, J.; Karakhanova, S. Reactive oxygen species in the immune system. Int. Rev. Immunol. 2013, 32, 249–270. [Google Scholar] [CrossRef] [PubMed]
- Mao, Y.; Wang, J.; Yu, F.; Li, Z.; Li, H.; Guo, C.; Fan, X. Ghrelin protects against palmitic acid or lipopolysaccharide-induced hepatocyte apoptosis through inhibition of MAPKs/iNOS and restoration of Akt/eNOS pathways. Biomed Pharm 2016, 84, 305–313. [Google Scholar] [CrossRef] [PubMed]
- Slomiany, B.L.; Slomiany, A. Ghrelin protection against lipopolysaccharide-induced gastric mucosal cell apoptosis involves constitutive nitric oxide synthase-mediated caspase-3 S-nitrosylation. Mediat. Inflamm. 2010, 2010, 280464. [Google Scholar] [CrossRef] [PubMed]
Disclaimer/Publisher’s Note: The statements, opinions and data contained in all publications are solely those of the individual author(s) and contributor(s) and not of MDPI and/or the editor(s). MDPI and/or the editor(s) disclaim responsibility for any injury to people or property resulting from any ideas, methods, instructions or products referred to in the content. |
© 2023 by the authors. Licensee MDPI, Basel, Switzerland. This article is an open access article distributed under the terms and conditions of the Creative Commons Attribution (CC BY) license (https://creativecommons.org/licenses/by/4.0/).







